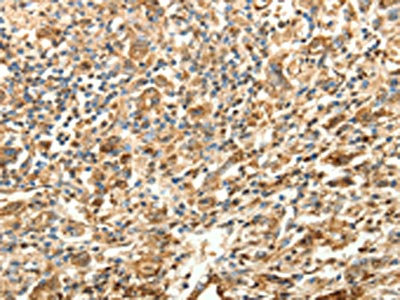

SLC25A11 Antibody
-
中文名稱:SLC25A11兔多克隆抗體
-
貨號:CSB-PA061492
-
規(guī)格:¥1100
-
圖片:
-
The image on the left is immunohistochemistry of paraffin-embedded Human esophagus cancer tissue using CSB-PA061492(SLC25A11 Antibody) at dilution 1/30, on the right is treated with fusion protein. (Original magnification: ×200)
-
The image on the left is immunohistochemistry of paraffin-embedded Human gastric cancer tissue using CSB-PA061492(SLC25A11 Antibody) at dilution 1/30, on the right is treated with fusion protein. (Original magnification: ×200)
-
Gel: 12%SDS-PAGE, Lysate: 40 μg, Lane: Human lymphoma tissue, Primary antibody: CSB-PA061492(SLC25A11 Antibody) at dilution 1/600, Secondary antibody: Goat anti rabbit IgG at 1/8000 dilution, Exposure time: 20 seconds
-
-
其他:
產品詳情
-
Uniprot No.:
-
基因名:SLC25A11
-
別名:SLC25A11; SLC20A4; Mitochondrial 2-oxoglutarate/malate carrier protein; OGCP; Solute carrier family 25 member 11
-
宿主:Rabbit
-
反應種屬:Human,Mouse,Rat
-
免疫原:Fusion protein of Human SLC25A11
-
免疫原種屬:Homo sapiens (Human)
-
標記方式:Non-conjugated
-
抗體亞型:IgG
-
純化方式:Antigen affinity purification
-
濃度:It differs from different batches. Please contact us to confirm it.
-
保存緩沖液:-20°C, pH7.4 PBS, 0.05% NaN3, 40% Glycerol
-
產品提供形式:Liquid
-
應用范圍:ELISA,WB,IHC
-
推薦稀釋比:
Application Recommended Dilution ELISA 1:1000-1:5000 WB 1:500-1:2000 IHC 1:25-1:100 -
Protocols:
-
儲存條件:Upon receipt, store at -20°C or -80°C. Avoid repeated freeze.
-
貨期:Basically, we can dispatch the products out in 1-3 working days after receiving your orders. Delivery time maybe differs from different purchasing way or location, please kindly consult your local distributors for specific delivery time.
-
用途:For Research Use Only. Not for use in diagnostic or therapeutic procedures.
相關產品
靶點詳情
-
功能:Catalyzes the transport of 2-oxoglutarate across the inner mitochondrial membrane in an electroneutral exchange for malate or other dicarboxylic acids, and plays an important role in several metabolic processes, including the malate-aspartate shuttle, the oxoglutarate/isocitrate shuttle, in gluconeogenesis from lactate, and in nitrogen metabolism. Maintains mitochondrial fusion and fission events, and the organization and morphology of cristae. Involved in the regulation of apoptosis. Acts as a tumor-suppressor gene implicated in the predisposition to metastatic paraganglioma.
-
基因功能參考文獻:
- The Network analyses identified SLC25A11expression in temporal cortex in patient with late-onset Alzheimer's disease. PMID: 28242297
- OGC as a model protein for understanding the transport mechanism of mitochondrial carriers. PMID: 23054077
- OGCP degrades through proteasome and lysosome degradation pathways. The degradation of parkin protein can promote the degradation of OGCP. PMID: 21500544
- Controlling MISC-1/OGC function allows regulation of mitochondrial morphology and cell survival decisions by the metabolic needs of the cell. PMID: 21448454
- data provide evidence for a role of the 2-oxoglutarate carrier as a glutathione transporting polypeptide PMID: 12939596
- porphyrin accumulation in mitochondria is mediated by OGC and porphyrins are able to competitively inhibit 2-oxoglutarate uptake into mitochondria PMID: 16920706
顯示更多
收起更多
-
亞細胞定位:Mitochondrion inner membrane; Multi-pass membrane protein.
-
蛋白家族:Mitochondrial carrier (TC 2.A.29) family
-
數據庫鏈接:
Most popular with customers
-
-
YWHAB Recombinant Monoclonal Antibody
Applications: ELISA, WB, IHC, IF, FC
Species Reactivity: Human, Mouse, Rat
-
Phospho-YAP1 (S127) Recombinant Monoclonal Antibody
Applications: ELISA, WB, IHC
Species Reactivity: Human
-
-
-
-
-